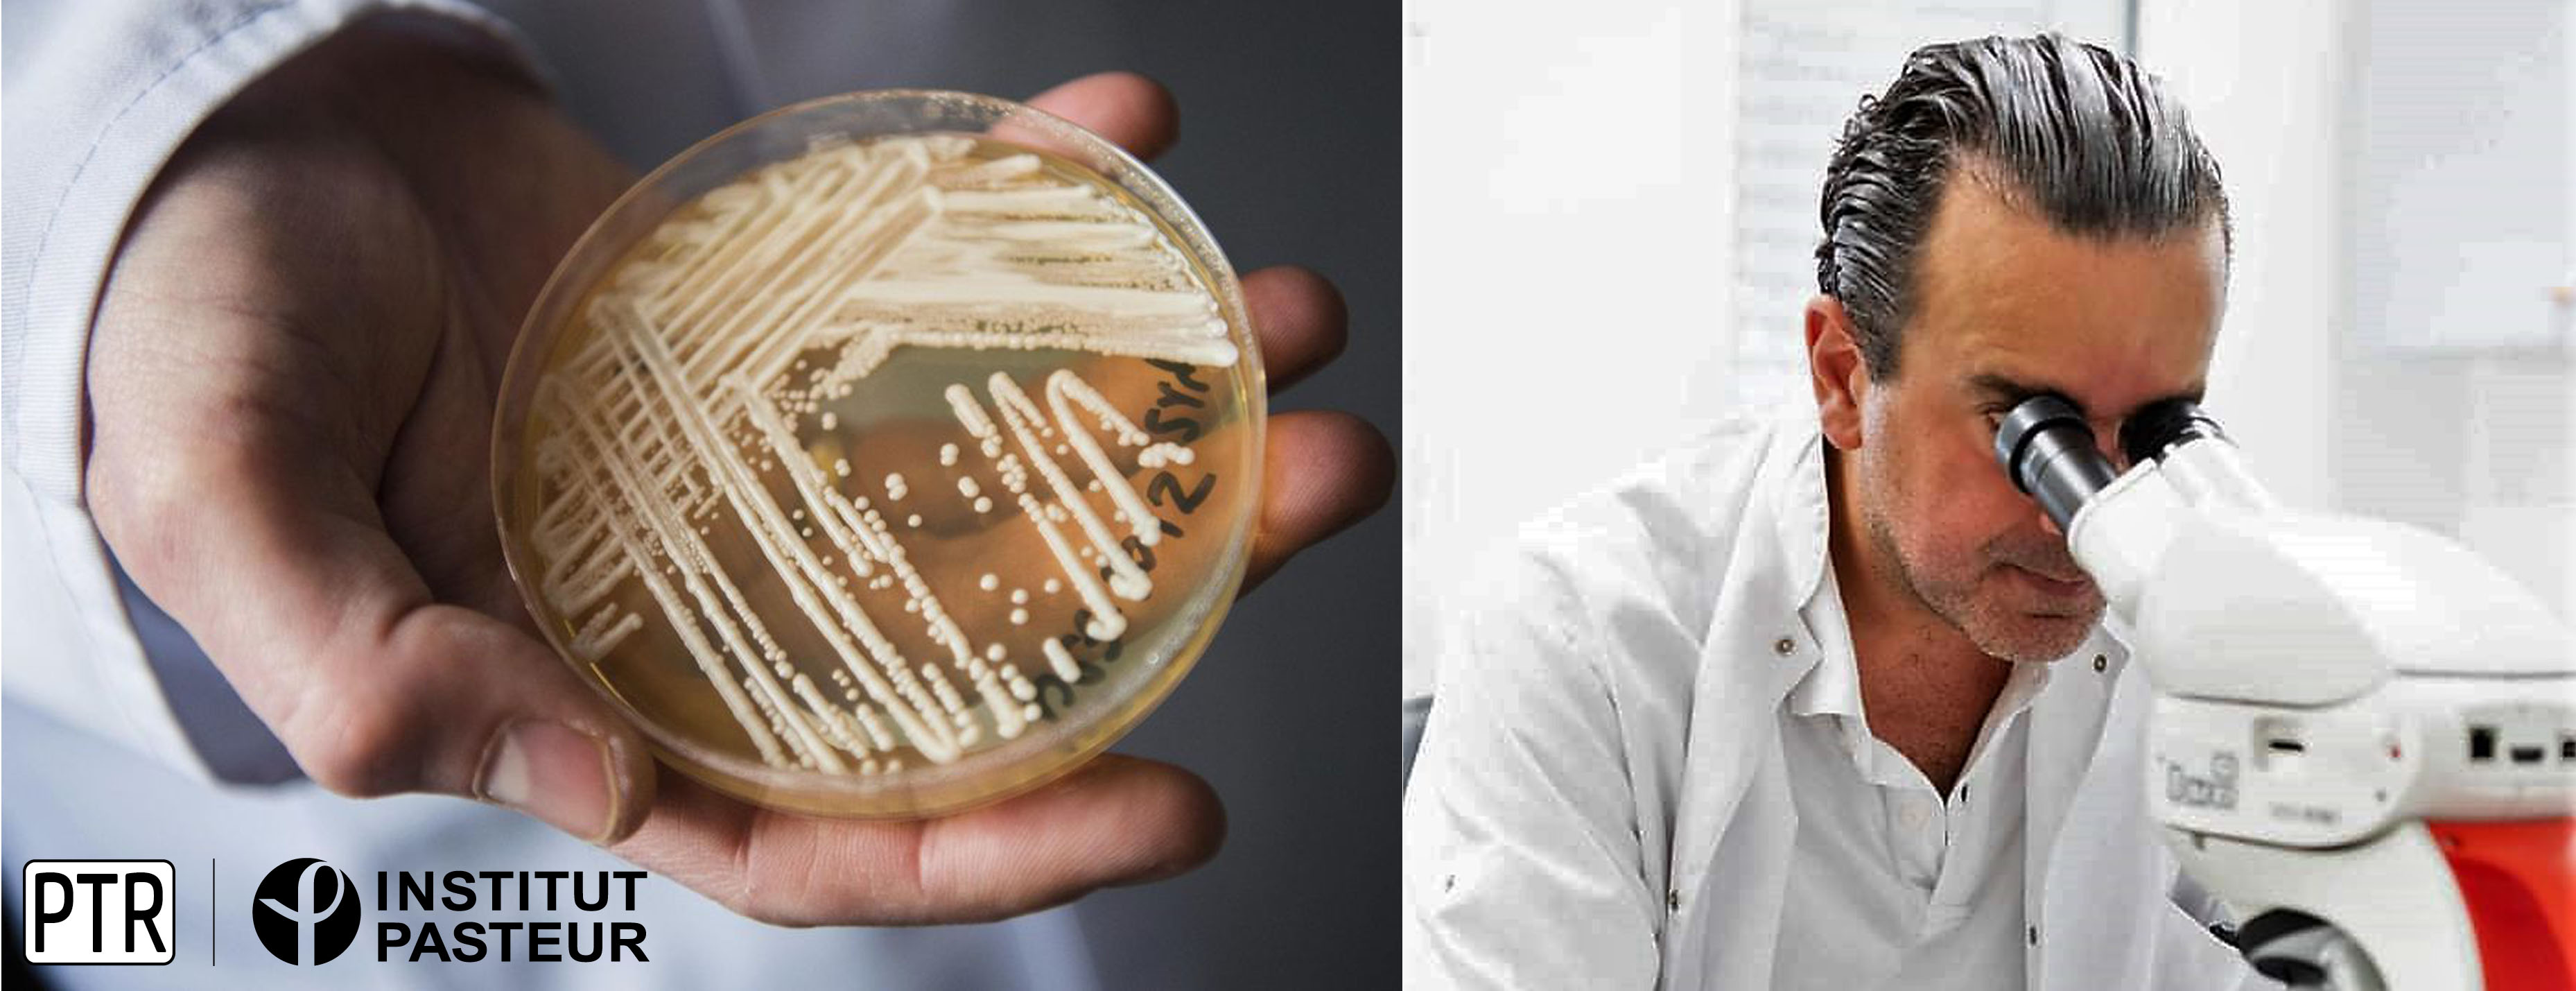

- Détails
- Affichages : 212
Dans le cadre des “visites d'experts” du projet PHINDaccess, une délégation de la plateforme technologique Biomics de l’Institut de Pasteur de Paris (IP) https://research.pasteur.fr/fr/team/biomics/

- Détails
- Affichages : 150
Deux jeunes chercheuses de l'Institut Pasteur de Tunis, Yosr Hamdi (Laboratoire de génomique biomédicale et oncogénétique) et Fatma Guerfali (Laboratoire de transmission,

- Détails
- Affichages : 159
L'Institut Pasteur de Tunis lance son Podcast, InScope! Découvrez le 1er épisode intitulé "Back to the future « l’Institut Pasteur de Tunis de 1893 à l’ère de l’#omique" avec une interview du Directeur Général Pr. Hechmi Louzir https://tinyurl.com/562r3624

- Détails
- Affichages : 245
In the frame of the WP7 «Performance Monitoring And Strategy For Sustainable Networking And Excellence” of the PHINDAccess project (H2020 programme) and in the collaboration with the grant office of Institut Pasteur de Tunis,

- Détails
- Affichages : 136
En juillet 2019, Lilia Romdhane, chercheuse associée au laboratoire de Génomique biomédicale et oncogénétique de l'Institut a été élue membre de l'"Arab-German Young Academy of Sciences and Humanities (AGYA).

- Détails
- Affichages : 162
Dans le cadre des activités du projet européen InSPIRES, la Boutique des Sciences de l'Institut Pasteur de Tunis a lancé un cycle de webinaires intitulé : "Les Boutiques des Sciences à l'Université"

- Détails
- Affichages : 267
L'institut Pasteur de Tunis et la Commune de la Marsa lancent un appel à projet commun innovant dans le cadre de la lutte contre la rage par le moyen des nouvelles technologies

- Détails
- Affichages : 737
L'Institut Pasteur de Tunis assure la réalisation de tests de diagnostic RT-PCR Covid-19. Le test est d'un montant de 170 DT. Le paiement se fait sur place, à la caisse de l'IPT

- Détails
- Affichages : 189
Dans le cadre de leur contribution à l'effort national de surveillance moléculaire du virus SARS-CoV-2, des équipes de l'Institut Pasteur de Tunis (IPT) travaillent ensemble,

- Détails
- Affichages : 157
Un workshop régional sur la rage a été organisé en ligne du 16 au 17 février 2021 par le Laboratoire de la Rage de l'Institut Pasteur de Tunis et le Laboratoire de la rage et de la faune sauvage de l'ANSES-Nancy.

- Détails
- Affichages : 153
Dans le cadre de la Journée Mondiale de l'Audition, l'Association Ichara en collaboration avec le Laboratoire de Génomique Biomédicale et Oncogénétique, l'Association Amicale des Syndicats des Surveillants de la Santé Publique,
- Détails
- Affichages : 177
Un consortium dirigé par des scientifiques des Instituts Pasteur de Tunis (Dr. Sadri Znaidi, coordinateur du projet), Paris (Dr. Marie-Elisabeth Bougnoux), Shanghai (Dr. Changbin Chen) et Séoul (Dr. David Shum)

- Détails
- Affichages : 210
Le laboratoire haute sécurité biologique P3, appelé Laboratoire Rodolphe Mérieux de Tunisie, a été inauguré à l’Institut Pasteur de Tunis (IPT), ce mercredi 27 octobre 2021.

- Détails
- Affichages : 208
The PHINDaccess project organizes its second hackathon entitled “The study of the genetic susceptibility to COVID19 and SARS-CoV-2 human host pathogen interactions”, on October 28th-29th, 2021 at the Institut Pasteur de Tunis.

- Détails
- Affichages : 214
Le rôle de l'IPT dans la gestion de l'épidémie Covid-19 en Tunisie :
L'IPT contribue à la gestion de l'épidémie de Covid-19 en participant au plan national de riposte mis en place par le Ministère de la Santé, sur deux volets :

- Détails
- Affichages : 184
Mardi 9 juin 2020, le ministre de la Santé, M. Abdelatif Mekki, accompagné d’une délégation du ministère de la Santé, a effectué une visite à l’Institut Pasteur de Tunis.

- Détails
- Affichages : 180
L'Institut Pasteur de Tunis coordonne depuis août 2021, un projet autour de l'Infection au SRAS-CoV2 chez la femme enceinte en Tunisie. Il s'agit d'une étude prospective pour l'investigation clinico-biologique de l'impact de l'infection sur la santé de la mère et sur l'issue de la grossesse. (PREG-CoV).

- Détails
- Affichages : 214
Passionnée par la thématique de la transmission des maladies génétiques, Roukaya YAAKOUBI réalise sa thèse à l'Institut Pasteur de Tunis sur les déficits immunitaires primitifs (DIPs), maladies génétiques du système immunitaire.

- Détails
- Affichages : 180
Vous êtes une association ou une organisation à but non lucratif ?
Vos activités touchent le domaine de la Santé ?

- Détails
- Affichages : 182
Au cours des trois années du projet PHINDaccess une série de formations sera délivrée afin de sensibiliser et développer les compétences en matière d'Open Science et de reproductibilité dans les domaines de la science,

- Détails
- Affichages : 159
Suite à la publication d'un article de presse le 30 mai 2019, dans certains journaux électroniques contenant des informations selon lesquelles une peine de cinq ans d'emprisonnement a été infligée à "l'ancien directeur de l'Institut Pasteur,

- Détails
- Affichages : 311
Mardi 22 janvier 2019, Jean-François Delfraissy, président du Comité National Consultatif d'Ethique (CNCE) français s'est rendu à l'IPT, accompagné de la directrice de communication du CNCE,

- Détails
- Affichages : 172
L'Institut Pasteur de Tunis (IPT) et la Direction Culture, Science et Société de l'Université de Lyon en tant que partenaires du consortium du projet H2020 InSPIRES organisent une école de printemps autour des Boutiques des Sciences (BdS) les 22 et 23 avril 2019 à l'IPT.

- Détails
- Affichages : 275
Présentation de l’école de printemps
Dans le cadre du projet européen InSPIRES, l’Institut Pasteur de Tunis et l’Université de Lyon organisent une école de printemps autour des Boutiques des Sciences.

- Détails
- Affichages : 240
Safa Boujemaa étudiante en thèse sous la direction de Boutheina Mardassi a obtenu le prix du meilleur poster lors des Journées internationales de biotechnologie qui se sont déroulées du 20 au 23 décembre 2018 à Sousse.

- Détails
- Affichages : 172
Le lancement du projet PHINDaccess s'est déroulé du 5 au 7 novembre 2018 à Tunis. Financé par la commission européenne dans le cadre du programme H2020, suite à l'appel d'offre WIDESPREAD-05-2017 - Twinning, PHINDaccess est un projet coordonné par l'Institut Pasteur de Tunis.

- Détails
- Affichages : 184
La réunion de lancement du projet PAQ-Collabora s'est déroulée le 3 décembre 2018 à l'IPT.
Porté par l'Institut Pasteur de Tunis (Pr. Héla Kallel), le projet réuni également la Biotechpole Sidi Thabet et les laboratoires pharmaceutiques Teriak.

- Détails
- Affichages : 246
Le projet InSPIRES, le comité d'éthique de l'Institut Pasteur de Tunis (IPT) et le Regional Training Center (RTC), organisent un webinar le vendredi 16 Novembre, à 15 heures d'une durée de 1h00 autour de « l'éthique de la recherche biomédicale».

- Détails
- Affichages : 149
Le Prix Sanofi de la Recherche en Santé récompense toute recherche dont le sujet restera au choix du ou des auteurs dans les domaines relevant de la santé et de la bioéthique (études cliniques, bomédicales, fondamentales...)

- Détails
- Affichages : 254
Les techniciens biologistes de l'Institut Pasteur de Tunis se sont distingués lors de la 61ème Journée de l’Association Amicale des Surveillants de la Santé

- Détails
- Affichages : 162
Une équipe du laboratoire des venins et biomolécules thérapeutiques a obtenu le 2ème Prix de Thèse CMCU, lors d'une ceremonie qui s est deroulee a Tabarka, lundi 24 septembre 2018.

- Détails
- Affichages : 154
Un cours de haut niveau scientifique de « Bioinformatique et d'Analyse des Génomes » a été organisé à l'Institut Pasteur de Tunis du 10 Septembre aux 14 Décembre 2018 (https://webext.pasteur.fr/tekaia/BCGAIPT2018.html).

- Détails
- Affichages : 260
Après la réussite du 1er Colloque Jeunes Chercheurs de l'Institut Pasteur de Tunis 2016, l'association des Jeunes Chercheurs de l'IPT organise le 2ème Colloque Jeunes Chercheurs de l'Institut Pasteur de Tunis, les 18,19 et 20 Avril 2018 à l'IPT.

- Détails
- Affichages : 181
Sonia Abdelhak, biologiste principale et responsable du laboratoire de génomique biomédicale et oncogénétique a été sélectionnée parmi les 200 femmes francophones

- Détails
- Affichages : 294
Suite à sa sélection en septembre dernier comme lauréate du Next Einstein forum, Rym Kefi, a participé du 26 au 28 mars 2018 aux journées scientifiques "NEF global Gathering " qui ont eu lieu à Kigali, Rwanda.

- Détails
- Affichages : 232
La réunion de lancement du projet Leishield-MATI s'est tenue à Tunis du 7 au 9 mai 2018.
Financé par le programme de financement européen de la Recherche H2020, le projet est coordonné par l'Institut Pasteur à Paris.

- Détails
- Affichages : 146
Le 28 septembre 2018, à la Cité de la Culture, la Nuit des Chercheurs s'est déroulée pour la première fois en Tunisie.

- Détails
- Affichages : 201
Maghreb sub-regional Consultation on Arab Charter of Ethics in Scientific Research and Technology,
Ramada Plaza Tunis, Tunisia, July 27, 2018

- Détails
- Affichages : 173
La section de l'Institut Pasteur de Tunis de l'Association Amicale des Surveillants de la Santé Publique fête ses dix ans.
Dans ce cadre, l'association organise une journée scientifique sous le thème "Maladies Emergentes et Santé Publique" et ce le Samedi 12 Mai 2018 à l'Institut Pasteur de Tunis.

- Détails
- Affichages : 189
Vous êtes une organisation impliquée dans les thématiques de santé, d'environnement ou d'accompagnement de populations vulnérables ?
Plus d'articles...
- Célébration de la journée mondiale de l’immunologie, institut pasteur de tunis, 29 avril 2018
- Retour sur le cours "Bioinformatics and genome analysis"
- Signalisation pro-apoptotique et non apoptotique de TRAIL : un choix cornélien pour son exploitation en oncologie
- 2ème annonce des 3ème Journées Franco-Maghrébines de Parasitologie-Mycologie




